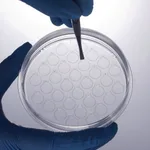

VWR 캡이 있는 마이크로 원심분리 튜브, VWR 표준 라인
상품 한눈에 보기
고품질 USP Class 6 감마 내성 PP로 제작된 투명 마이크로 원심분리 튜브. 0.5, 1.5, 2.0 ml 용량 선택 가능. 최대 25000×g 회전, 오토클레이브 및 동결 가능. DNase/RNase-free, 비발열성. TSE/BSE-free 인증 및 재밀봉 가능한 포장.
브랜드: VWR
✨AI 추천 연관 상품
AI가 분석한 이 상품과 연관된 추천 상품들을 확인해보세요
연관 상품을 찾고 있습니다...
VWR 캡이 있는 마이크로 원심분리 튜브 (VWR 표준 라인)
캡이 있는 마이크로 원심분리 튜브는 아주 투명하고 고품질의 USP Class 6 감마 내성 폴리프로필렌(PP)으로 제작되었습니다. 반복적인 캡 잠금을 견디며, 끓는 동안에도 터지지 않는 포지티브 밀봉 구조를 갖추고 있습니다. 모든 표준 로터에 적합합니다.
주요 특징
- 3가지 용량: 0.5 ml, 1.5 ml, 2.0 ml
- 새겨진 눈금으로 정확한 용량 측정 가능
- 매끄럽고 반투명한 몸체와 평평한 캡
- 명확하고 읽기 쉬운 마킹 영역 제공
- 최대 25,000 ×g까지 원심분리 가능
- 121 °C에서 오토클레이브 가능, -80 °C까지 동결 가능
- DNase-/RNase-free 및 비발열성
- 반복적인 캡 잠금에도 견디는 구조
인증
- TSE/BSE-free 인증 완료
포장 정보
- 내구성 있는 재밀봉 지퍼 백 포장
- 개별 라벨 부착으로 로트 간 추적 가능
제품 사양
| 항목 | 내용 |
|---|---|
| 재질 | USP Class 6 감마 내성 PP |
| 용량 | 0.5 ml / 1.5 ml / 2.0 ml |
| 최대 회전속도 | 25,000 ×g |
| 온도 범위 | -80 °C ~ 121 °C (오토클레이브 가능) |
| 인증 | TSE/BSE-free, DNase-/RNase-free, 비발열성 |
| 포장 형태 | 재밀봉 가능한 지퍼 백, 개별 라벨 부착 |
배송/결제/교환/반품 안내
배송 정보
| 기본 배송비 |
| 교환/반품 배송비 |
|
|---|---|---|---|
| 착불 배송비 |
| ||
| 교환/반품 배송비 |
| ||
결제 및 환불 안내
| 결제수단 |
|
|---|---|
| 취소 |
|
| 반품 |
|
| 환급 |
|
교환 및 반품 접수
| 교환 및 반품 접수 기한 |
|
|---|---|
| 교환 및 반품 접수가 가능한 경우 |
|
| 교환 및 반품 접수가 불가능한 경우 |
|
교환 및 반품 신청
| 교환 절차 |
|
|---|---|
| 반품 절차 |
|
문의 0
로그인 후 문의를 할 수 있습니다.